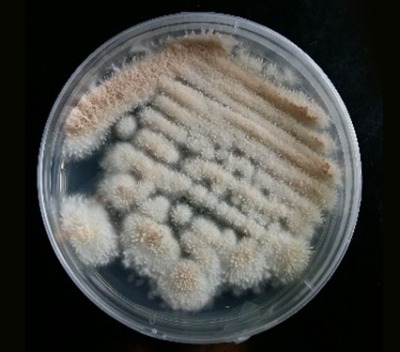

|
สำนักงานจัดการสิทธิเทคโนโลยี Technology Licensing Office |
 |
 |
สำนักงานจัดการสิทธิเทคโนโลยี Technology Licensing Office |
 |

| นักวิจัย นางสาวจีรภา ปัญญาศิริ และ ดร.ไว ปทุมผาย |
|
| หน่วยงาน ศูนย์พันธุวิศวกรรมและเทคโนโลยีชีวภาพแห่งชาติ สำนักงานพัฒนาวิทยาศาสตร์และเทคโนโลยีแห่งชาติ |
|
| รูปแบบความร่วมมือที่เสนอ เสาะหาผู้รับอนุญาตใช้สิทธิ |
|
| สถานภาพทรัพย์สินทางปัญญา อนุสิทธิบัตร เลขที่ 22369 คำขออนุสิทธิบัตร เลขที่คำขอ 2503001361 ยื่นคำขอวันที่ 11 เมษายน 2568 |
|
| สถานะงานวิจัย ได้ต้นแบบระดับ pilot scale (TRL6) |
| ที่มา ข้อมูลเบื้องต้น ความสำคัญของปัญหา ประเทศไทยเป็นประเทศเกษตรกรรมที่เผชิญปัญหาแมลงศัตรูพืชระบาดรุนแรง โดยเฉพาะแมลงหวี่ขาวและหนอนใยผักที่สร้างความเสียหายเป็นวงกว้าง การกำจัดแมลงส่วนใหญ่ใช้สารเคมี ซึ่งส่งผลให้แมลงสร้างความต้านทานต่อสารฆ่าแมลงได้อย่างรวดเร็ว และก่อให้เกิดสารเคมีตกค้างที่เป็นอันตราย เชื้อราทำลายแมลง (Entomopathogenic fungi) จึงเป็นทางเลือกสำคัญในการใช้เป็นชีวผลิตภัณฑ์เพื่อทดแทนหรือลดการใช้สารเคมี ศูนย์พันธุวิศวกรรมและเทคโนโลยีชีวภาพแห่งชาติได้คัดเลือกเชื้อราสายพันธุ์ Cordyceps fumosorosea BCC 20180 (หรือ Isaria fumosorosea) ที่มีประสิทธิภาพสูง เชื้อราสายพันธุ์นี้สามารถฆ่าแมลงหวี่ขาวได้ถึง 100 เปอร์เซ็นต์ และฆ่าหนอนใยผักได้มากกว่า 80 เปอร์เซ็นต์ ซึ่งเป็นคุณสมบัติที่หาได้ยากในเชื้อราชนิดเดียวกัน |
| สรุปเทคโนโลยี เป็นการพัฒนาชีวผลิตภัณฑ์จากเชื้อราทำลายแมลงสายพันธุ์ไทย (C. fumosorosea BCC 20180) ที่คัดเลือกมาจากกว่า 100 สายพันธุ์ โดยครอบคลุมตั้งแต่กระบวนการรักษาสายพันธุ์ให้มีความรุนแรง (Virulence) ไปจนถึงกระบวนการผลิตสปอร์ ในปริมาณสูงบนอาหารแข็ง (ข้าวเสาไห้) ในระดับโรงงานต้นแบบ เพื่อใช้ในการควบคุมแมลงศัตรูพืชเศรษฐกิจที่สำคัญ เช่น แมลงหวี่ขาวและหนอนใยผัก โดยมีจุดเด่น ดังนี้ • ประสิทธิภาพสูงและกว้างขวาง • สายพันธุ์มีความรุนแรงสูง • กระบวนการผลิตระดับขยายขนาด • คุณภาพสปอร์คงที่ • อายุการเก็บรักษานาน • ความปลอดภัย • ต้นทุนต่ำ |
| สนใจสอบถามข้อมูล งานธุรกิจทรัพย์สินทางปัญญา สำนักงานจัดการสิทธิเทคโนโลยี (TLO) โทรศัพท์: 025647000 ต่อ 1357 โทรศัพท์มือถือ: tlo-ipb@nstda.or.th |